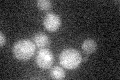
YKR050W
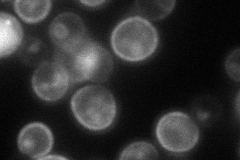
YKR050W
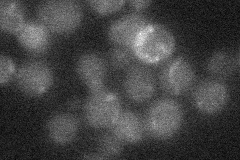
YKR050W
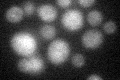
YKR050W

View description
Component of the Trk1p-Trk2p potassium transport system
Localization:
Intensity:
Fold change:
Significance:
-
C’ GFP library in SD
below threshold14.9 -
N' NOP1pr-GFP in SD

cell periphery47.3652 -
N' TEF2pr-mCherry in SD
cell periphery,vacuole55.5492 -
N' NATIVEpr-GFP in SD
below threshold14.0356 -
N' TEF2pr-VC and Cyto-VN in SD

cell periphery,punctate30.0942 -
C’ GFP library in SD+DTT
cytosol13.970.93No -
C’ GFP library in SD+H2O2

cytosol16.141.08No -
C’ GFP library in Starvation Media

cytosol17.831.19No -
C’ GFP library on the background of Pup2-DaMP

below threshold -
C’ GFP library on the background of CCT mutant

below threshold14.98981.00526No
